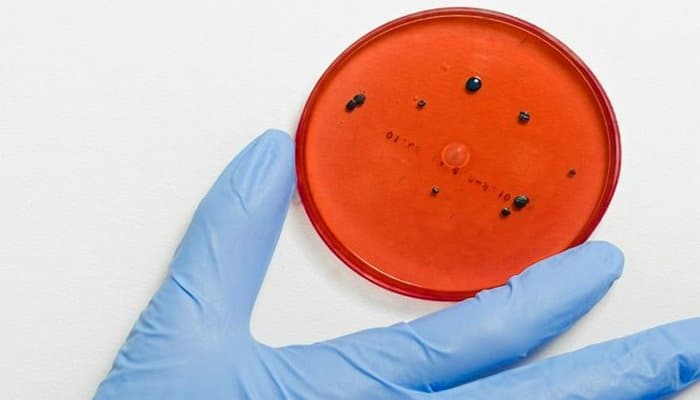

Startap antibiotikləri proqramlaşdırılan viruslarla əvəz etmək istəyir
Y Combinator biznes inkubatorunun məzunlarından biri dünyaya antibiotikə davamlı mikroorqanizmlərlə mübarizə üçün alternativ bir yol təklif edir, məhz bu koronavirus pandemiyasından əvvəl bəşəriyyət üçün əsas təhdidlərdən biri hesab olunurdu. İlk testlər uğurlu alındı.
İndi dünya o qədər kiçik bir orqanizmlə müharibədədir ki, onu yalnız mikroskop vasitəsilə görmək mümkündür. Ancaq dayandırılmasa, yaxın onilliklərdə milyonlarla insanı öldürəcəkdir. "ToxCrunch" yazır ki, söhbət COVID-19-dan deyil, davamlı bakteriyalardan gedir.
Hazırda dünyada hər il 700.000 insan bakterial infeksiyadan ölür. Heç bir şey edilməzsə, 2050-ci ilə qədər bu say 10 milyona çatacaq, BMT ekspertləri bildirirlər. Problem ondadır ki, müasir tibb çox sayda antibiotik təyin edir. Bundan əlavə, onlar daim heyvandarlıqda istifadə olunur. Bununla birlikdə, antibiotiklər pis bakteriyaların çoxunu deyil, hamısını öldürür. Və sağ qalanlar güclənir.
Ens.az bildirir ki, Amerikadakı biotech startapı Felix, davamlı bakterial infeksiyaların yayılmasını özündə ehtiva edən bir üsul tapdığını bildirir - bunlar virusdur. Qurucuları tərəfindən hazırlanan açar bir texnologiya, virusların bakteriyalardakı müəyyən yerlərə göndərilməsinə imkan verir. Bu yalnız patogenləri öldürmür, həm də onların inkişaf etmək və daha da sabit olmaq qabiliyyətini dayandırır.
Startap ilk növbədə fibrozdan əziyyət çəkənlər üçün bakterial infeksiya müalicəsini inkişaf etdirməyi planlaşdırır, çünki bu xəstələr ağciyər infeksiyasının öhdəsindən gəlmək üçün demək olar ki, daim antibiotik qəbul etməlidirlər.
Feliks artıq on nəfərlik bir qrupda öz texnikasının kiçik ilkin sınağını uğurla keçirib. Təsisçilər, onların yanaşmasının ənənəvi antibiotiklərin inkişafından daha sürətli və daha ucuz olduğunu iddia edir. Növbəti addım 30 nəfərlə bir təcrübə, sonra isə - ABŞ-ın Sanitariya Departamentinin tələblərinə uyğunluq üçün tədqiqat modelinin və geniş miqyaslı testlərin hazırlanması olmalıdır.
Tədqiqatçılar müqavimətli bakteriyalarla mübarizədə kömək üçün süni intellektə müraciət etdilər. Maşına 2500 təbii və sintez edilmiş antibiotiklərin atom və molekulyar quruluşu haqqında məlumat verərək, vərəmin törədicisi də daxil olmaqla bir çox dərmana davamlı bakteriyaların öhdəsindən gələ biləcək bir maddə əldə etdilər.
Mənbə: hightech.plus

























Şərhlər
Şərhləri göstər Şərhləri gizlət